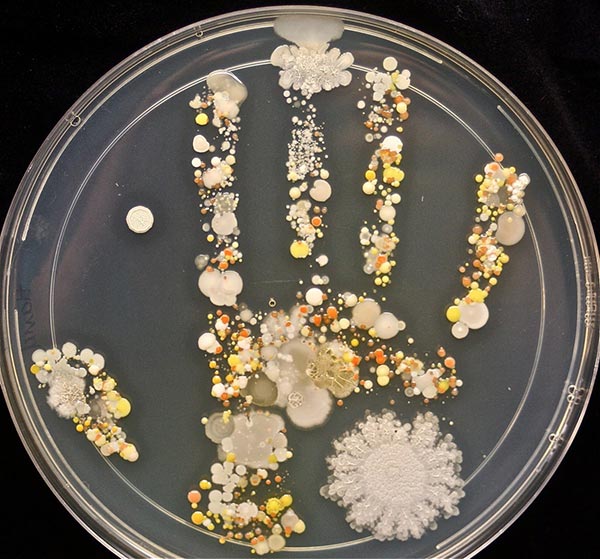
เชื้อโรค

คุณแม่นักชีววิทยาทดลองเพาะเชื้อโรคจากฝ่ามือลูกตัวเอง เตือนสติให้เห็นว่าล้างมือบ่อย ๆ กันเถอะ ถ้าไม่อยากป่วยเพราะเชื้อโรคบนร่างกายเราเอง !
แม้เราจะตระหนักกันดีอยู่แล้วว่ามือที่สัมผัสกับสิ่งของรอบตัวจะมีเชื้อโรคปนเปื้อนอยู่มากพอสมควร ดังนั้นการใช้มือสัมผัสใบหน้า หรือการใช้มือหยิบจับอาหารเข้าปาก ไม่ใช่สิ่งที่ถูกสุขอนามัยนัก แต่กระนั้นหลายคนก็ทำเป็นมองข้ามการล้างมือไปเพราะคิดว่าเชื้อโรคคงไม่เยอะเท่าไร งั้นเอาเป็นว่าลองมาดูภาพฝ่ามือบนจานเพาะเชื้อโรคให้เห็นกันชัด ๆ ไปเลยว่า เชื้อโรคบนฝ่ามือ จะมีมากขนาดไหน รับรองค่ะว่าถ้าได้ดูภาพเชื้อโรคบนมือแล้วจะร้องอี๋แล้วอยากล้างมือให้สะอาดกันมากกว่าเดิมอีกหลายเท่าเลยล่ะ !
ทั้งนี้ Tasha ได้อธิบายผ่านทวิตเตอร์ของเธอว่า เชื้อโรคบนฝ่ามือ (นิ้วโป้งและนิ้วนาง) ที่เห็นจะเป็นเชื้อแบคทีเรียสเตรปโตคอกคัส (Streptococus spp.) และเชื้อแบคทีเรียไมโครคอกคัส (Micrococcus) ซึ่งก็เป็นเชื้อแบคทีเรียที่อาศัยเป็นปกติอยู่บนร่างกายคนหรือสัตว์ และแม้เชื้อแบคทีเรียเหล่านี้จะไม่ก่อโรค แต่ก็เป็นเชื้อแบคทีเรียที่เป็นสาเหตุให้อาหารเน่าเสียเร็วขึ้นได้
- ล้างมือถูกวิธี เลี่ยงเชื้อโรคจากห้องน้ำสาธารณะให้ไกล
ขอขอบคุณข้อมูลจาก
ทวิตเตอร์ Tasha Sturm
medicaldaily
ภาพฝ่ามือบนจานเพาะเชื้อที่เราจะได้เห็นต่อไปนี้เป็นภาพจากทวิตเตอร์ Tasha Sturm คุณแม่นักชีววิทยาในห้องปฏิบัติการทางวิทยาศาสตร์ของ Cabrillo College เธอได้นำฝ่ามือของลูกชายวัย 8 ขวบ หลังจากเขาออกไปเล่นนอกบ้านมาประทับไว้บนจานเพาะเลี้ยงเชื้อ และ 2-3 วันถัดมาเราก็ได้เห็นเชื้อโรคบนฝ่ามือที่จะอี๋ก็อี๋ จะมองว่าเป็นงานอาร์ตก็ได้อีกแหละ
ส่วนบริเวณกลางฝ่ามือจะเป็นเชื้อราประเภทไรซอยด์ (Rhizoid)
ที่เจริญเติบโตได้อย่างรวดเร็วบริเวณอุ้มมือและกลางฝ่ามือ และยังมีเชื้อรา
เชื้อแบคทีเรียชนิดอื่น ๆ
กระจายอยู่แทบจะทุกพื้นที่ของฝ่ามืออย่างที่เราเห็นเป็นจุดสี ๆ นั่นแหละค่ะ
ยิ่งซูมใกล้ ๆ เชื้อโรคบนฝ่ามือยิ่งน่ายี้มากขึ้นอีกหลายเท่าตัว ฉะนั้นเราก็ควรล้างมือให้สะอาดทุกครั้งหลังทำกิจกรรมอะไรก็ตาม รวมไปถึงก่อนรับประทานอาหารทุกครั้งด้วยนะคะ อ้อ ! ที่สำคัญอย่าลืมลางมือด้วยวิธีล้างมือที่ถูกต้อง เพื่อความสะอาดและถูกสุขอนามัย ช่วยเซฟเราให้ปลอดภัยจากเชื้อก่อโรคใกล้ตัวนั่นเอง
- ล้างมือถูกวิธี เลี่ยงเชื้อโรคจากห้องน้ำสาธารณะให้ไกล
ขอขอบคุณข้อมูลจาก
ทวิตเตอร์ Tasha Sturm
medicaldaily